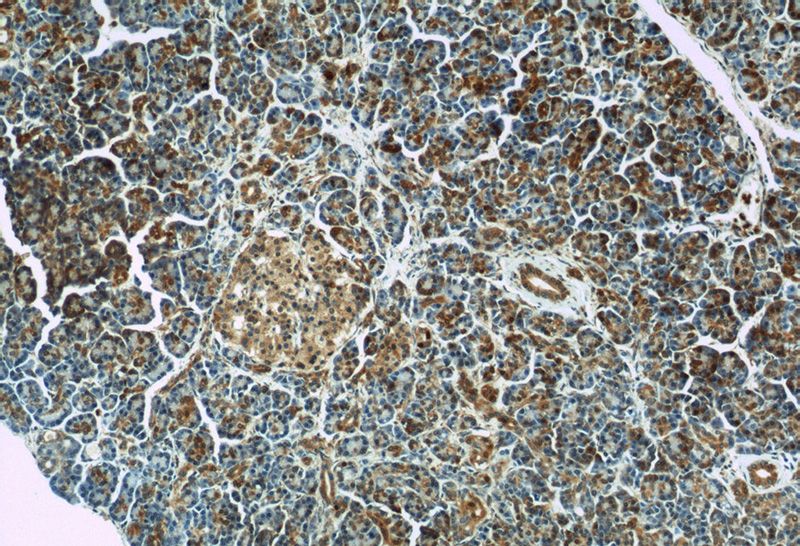
Immunohistochemistry of paraffin-embedded human pancreas slide using Catalog No:110935(GEFT-Specific Antibody) at dilution of 1:100
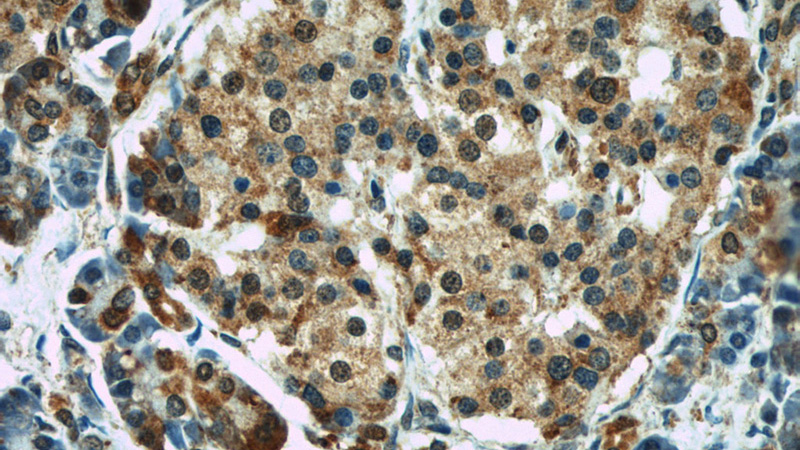
Immunohistochemistry of paraffin-embedded human pancreas slide using Catalog No:110935(GEFT-Specific Antibody) at dilution of 1:100

-
Product Name
GEFT-Specific antibody
- Documents
-
Description
GEFT-Specific Rabbit Polyclonal antibody. Positive WB detected in mouse skeletal muscle tissue, HEK-293 cells, mouse heart tissue, mouse liver tissue. Positive IP detected in mouse brain tissue. Positive IHC detected in human pancreas tissue, human skeletal muscle tissue. Observed molecular weight by Western-blot: 64 kDa
-
Tested applications
ELISA, WB, IHC, IP
-
Species reactivity
Human,Mouse,Rat; other species not tested.
-
Alternative names
GEFT antibody; p63RhoGEF antibody; RhoA/RAC/CDC42 exchange factor antibody
-
Isotype
Rabbit IgG
-
Preparation
This antibody was obtained by immunization of Peptide (Accession Number: NM_182947). Purification method: Antigen affinity purified.
-
Clonality
Polyclonal
-
Formulation
PBS with 0.02% sodium azide and 50% glycerol pH 7.3.
-
Storage instructions
Store at -20℃. DO NOT ALIQUOT
-
Applications
Recommended Dilution:
WB: 1:500-1:5000
IP: 1:500-1:5000
IHC: 1:20-1:200
-
Validations

mouse skeletal muscle tissue were subjected to SDS PAGE followed by western blot with Catalog No:110935(GEFT-Specific antibody) at dilution of 1:1500

IP Result of anti-GEFT-Specific (IP:Catalog No:110935, 4ug; Detection:Catalog No:110935 1:1500) with mouse brain tissue lysate 8000ug.
Immunohistochemistry of paraffin-embedded human pancreas slide using Catalog No:110935(GEFT-Specific Antibody) at dilution of 1:100
Immunohistochemistry of paraffin-embedded human pancreas slide using Catalog No:110935(GEFT-Specific Antibody) at dilution of 1:100
-
Background
GEFT, also named as p63RhoGEF, may play a role in actin cytoskeleton reorganization in different tissues since its activation induces formation of actin stress fibers. It works as a guanine nucleotide exchange factor for Rho family of small GTPases. GETF links specifically G alpha q/11-coupled receptors to RHOA activation. GEFT may be an important regulator of processes involved in axon and dendrite formation. In neurons seems to be an exchange factor primarily for RAC1. It is involved in skeletal myogenesis.
-
References
- Bryan BA, Mitchell DC, Zhao L. Modulation of muscle regeneration, myogenesis, and adipogenesis by the Rho family guanine nucleotide exchange factor GEFT. Molecular and cellular biology. 25(24):11089-101. 2005.
- Wuertz CM, Lorincz A, Vettel C, Thomas MA, Wieland T, Lutz S. p63RhoGEF--a key mediator of angiotensin II-dependent signaling and processes in vascular smooth muscle cells. FASEB journal : official publication of the Federation of American Societies for Experimental Biology. 24(12):4865-76. 2010.
- Mitchell DC, Bryan BA, Liu L. GEFT, A Rho family guanine nucleotide exchange factor, regulates lens differentiation through a Rac1-mediated mechanism. Current molecular medicine. 11(6):465-80. 2011.
- Momotani K, Artamonov MV, Utepbergenov D, Derewenda U, Derewenda ZS, Somlyo AV. p63RhoGEF couples Gα(q/11)-mediated signaling to Ca2+ sensitization of vascular smooth muscle contractility. Circulation research. 109(9):993-1002. 2011.
- Kant S, Swat W, Zhang S. TNF-stimulated MAP kinase activation mediated by a Rho family GTPase signaling pathway. Genes & development. 25(19):2069-78. 2011.
- Hayashi A, Hiatari R, Tsuji T, Ohashi K, Mizuno K. p63RhoGEF-mediated formation of a single polarized lamellipodium is required for chemotactic migration in breast carcinoma cells. FEBS letters. 587(6):698-705. 2013.
- Calò LA, Davis PA, Pagnin E. Increased level of p63RhoGEF and RhoA/Rho kinase activity in hypertensive patients. Journal of hypertension. 32(2):331-8. 2014.
- Artamonov MV, Momotani K, Stevenson A. Agonist-induced Ca2+ sensitization in smooth muscle: redundancy of Rho guanine nucleotide exchange factors (RhoGEFs) and response kinetics, a caged compound study. The Journal of biological chemistry. 288(47):34030-40. 2013.
Related Products / Services
Please note: All products are "FOR RESEARCH USE ONLY AND ARE NOT INTENDED FOR DIAGNOSTIC OR THERAPEUTIC USE"
